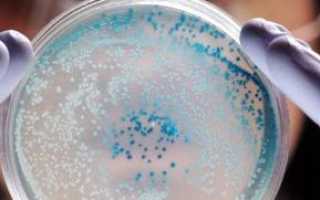

Микоплазмоз — инфекционное заболевание, вызываемое микоплазмами, поражающими мочеполовую систему женщин и мужчин. Хотя микоплазмы входят в нормальную микрофлору, их избыточное размножение может привести к уретриту, вагиниту и другим воспалительным процессам. В статье рассмотрим основные симптомы микоплазмоза, диагностику, методы лечения и профилактики, что поможет читателям распознать заболевание и предпринять необходимые меры.
Причины возникновения
Возбудителями урогенитального микоплазмоза являются два ключевых микроорганизма:
- микоплазма хоминис
- уреаплазма уреалитикум.
Эти патогены были впервые обнаружены в 1937 и 1954 годах соответственно. С тех пор начались активные исследования по разработке методов лечения, направленных на их уничтожение, что позволяет контролировать развитие заболевания.
Уреаплазмы имеют различные биовары. Исследования показывают, что разные биовары могут вызывать как острое, так и хроническое воспаление.
Тем не менее, микоплазмоз урогенитального типа характеризуется частыми рецидивами, склонностью к осложнениям и прогрессированием заболевания, часто при скрытой клинической картине.
Однако не у всех людей развивается воспалительный процесс – существуют случаи носительства. Например, у женщин носительство уреаплазмоза наблюдается в 40-80% случаев, а микоплазмоза – в 20-50%. У мужчин распространенность носительства несколько ниже.
Заражение микоплазмами и уреаплазмами может происходить следующими способами:
- Половой путь – основной
- Бытовой путь – возможен, но встречается крайне редко
- Ятрогенный путь, который возникает при недостаточной стерилизации медицинских инструментов в акушерско-гинекологических учреждениях. Поэтому рекомендуется использовать индивидуальные наборы.
Микоплазмоз является одной из распространенных инфекций, вызванных микоплазмами, и может затрагивать как женщин, так и мужчин. Врачи отмечают, что у женщин симптомы могут проявляться в виде вагинальных выделений, зуда и дискомфорта, в то время как у мужчин чаще наблюдаются болезненные ощущения при мочеиспускании и выделения из уретры. Важно понимать, что многие пациенты могут не проявлять симптомов, что затрудняет диагностику.
Лечение микоплазмоза обычно включает антибиотики, однако выбор препарата зависит от индивидуальных особенностей пациента и чувствительности возбудителя. Врачи подчеркивают важность завершения курса лечения, даже если симптомы исчезли, чтобы избежать рецидивов. Профилактика инфекции включает соблюдение правил личной гигиены, использование барьерных методов контрацепции и регулярные медицинские осмотры. Врачи настоятельно рекомендуют не игнорировать симптомы и обращаться за медицинской помощью при первых признаках инфекции.
Микоплазмоз является одной из распространенных инфекций, вызываемых микоплазмами, и может проявляться различными симптомами у мужчин и женщин. Эксперты отмечают, что у женщин заболевание часто сопровождается вагинальными выделениями, зудом и болями внизу живота, в то время как у мужчин могут наблюдаться дискомфорт при мочеиспускании и выделения из уретры. Важно отметить, что многие пациенты могут быть бессимптомными, что усложняет диагностику. Лечение обычно включает антибиотики, однако выбор препарата зависит от чувствительности микоплазм. Профилактика заключается в соблюдении правил личной гигиены и безопасных половых практик. Регулярные медицинские осмотры также играют ключевую роль в раннем выявлении и предотвращении осложнений.

Симптомы микоплазмоза у женщин и мужчин
Развитие воспалительного процесса, который вызывается микоплазмами и уреаплазмами, происходит при наличии следующих предрасполагающих факторов:
- общее снижение активности протекающих иммунных реакций
- гормональный дисбаланс
- истощающие общие заболевания.
У мужчин и женщин клинические симптомы микоплазмоза зависят от того, какой орган вовлечен в патологический процесс.
Основными нозологическими единицами урогенитального микоплазмоза являются:
- воспаление мочеиспускательного канала
- воспаление предстательной железы у мужчин
- воспаление лоханок и чашечек (пиелонефрит)
- мочекаменная болезнь, при которой основой образования камней является воспалительный осадок в почечных синусах, мочевом пузыре
- сальпингит – воспаление маточных труб
- сальпингоофорит – воспаление яичников и маточных труб, которые одновременно вовлекаются в патологический процесс
- некоторые формы метрита, склонные к хроническому течению.
При уретрите пациент предъявляет жалобы на боли и рези, которые возникают при мочеиспускании. Повышения температуры тела при этом состоянии нет. Лихорадка наблюдается, если в патологический процесс вовлекаются внутренние половые органы или почки.
При мочекаменной болезни могут возникать приступы почечной колики, которые обусловлены спастическим сокращением гладкой мускулатуры.
Сальпингоофорит и метрит провляется болями внизу живота, повышенной температурой, нарушением менструального цикла (см. причины задержки месячных) . Диагноз можно подтвердить с помощью влагалищного исследования. Для диагностики инфекций мочевых путей показано исследование мочи.
Для выставления окончательного диагноза рекомендуется провести дополнительные методы исследования:
- 1) Культуральный – посев отделяемого из мочеполовых органов на специальные среды. Колонии обычно появляются на 2-5-й день
- 2) Полимеразная цепная реакция, которая в настоящее время признана лидером среди основных диагностических тестов
- 3) Серологическое исследование – определение антител к микоплазмам и уреаплазмам разных классов, чтобы можно было судить об активности и давности воспалительного процесса.
| Симптом | Женщины | Мужчины |
|---|---|---|
| Уретрит | Частое мочеиспускание, жжение при мочеиспускании, выделения из уретры | Частое мочеиспускание, жжение при мочеиспускании, выделения из уретры |
| Цервицит | Выделения из влагалища (слизистые, гнойные), боль внизу живота, дискомфорт во время полового акта | – |
| Простатит | – | Боль в промежности, затрудненное мочеиспускание, боль внизу живота, лихорадка |
| Эпидидимит | – | Боль и отек в мошонке, лихорадка |
| Бесплодие | Нарушение менструального цикла, внематочная беременность, трубное бесплодие | Снижение количества и качества спермы, бесплодие |
| Воспаление суставов (артрит) | Боль и припухлость в суставах | Боль и припухлость в суставах |
| Высыпания на коже | – | – |
| Лечение | Антибиотики (тетрациклины, макролиды), противовоспалительные препараты | Антибиотики (тетрациклины, макролиды), противовоспалительные препараты |
| Профилактика | Безопасный секс, использование презервативов, своевременное лечение инфекций мочеполовой системы | Безопасный секс, использование презервативов, своевременное лечение инфекций мочеполовой системы |
Интересные факты
Вот несколько интересных фактов о микоплазмозе:
-
Разнообразие микоплазм: Микоплазмы — это группа бактерий, которые не имеют клеточной стенки, что делает их устойчивыми к многим антибиотикам, направленным на уничтожение клеточных стенок бактерий. Наиболее известные виды, вызывающие заболевания у человека, — это Mycoplasma genitalium и Mycoplasma hominis, которые могут вызывать инфекции мочеполовой системы.
-
Скрытые симптомы: У многих людей, инфицированных микоплазмами, симптомы могут отсутствовать или быть очень слабыми. Это делает диагностику сложной, и инфекция может оставаться невыявленной в течение длительного времени. У женщин это может привести к серьезным осложнениям, таким как воспалительные заболевания органов малого таза, если инфекция не будет своевременно выявлена и лечена.
-
Профилактика и лечение: Профилактика микоплазмоза включает в себя использование барьерных методов контрацепции, таких как презервативы, а также регулярные медицинские осмотры и тестирование на инфекции, передающиеся половым путем. Лечение обычно включает антибиотики, но важно учитывать, что некоторые штаммы микоплазм могут быть устойчивыми к стандартным антибиотикам, что требует индивидуального подхода к терапии.

Влияние микоплазмоза на беременность
Следует подчеркнуть, что микоплазмы и уреаплазмы способны преодолевать фетоплацентарный барьер. Поэтому уже на сроке 12-20 недель их можно обнаружить в околоплодных водах.
Такое внутриутробное заражение часто фиксируется в следующих ситуациях:
- преждевременные роды и недоношенность
- преждевременное излитие околоплодных вод.
Эти микроорганизмы могут достигать плода двумя основными путями:
- через плаценту (трансплацентарный путь)
- восходящим путем, поднимаясь из нижних отделов половых органов в верхние. Поэтому крайне важно проводить санацию влагалища.
Риск заражения внутриутробного плода составляет примерно 15-50%. Поэтому своевременное обследование как женщины, так и мужчины до зачатия имеет большое значение для предотвращения серьезных акушерских осложнений.
Кроме того, стоит отметить, что микоплазмы и уреаплазмы негативно влияют на возможность зачатия. Они выявляются у 50% женщин, страдающих бесплодием.
Это связано с несколькими механизмами:
- Отрицательное воздействие на сперматозоиды или яйцеклетки, что приводит к их морфологическим аномалиям.
- Развитие воспалительных процессов в области малого таза, что может привести к непроходимости маточных труб.
- Нарушение нормальных пролиферативных и секреторных процессов в эндометрии, что может вызвать отторжение оплодотворенной яйцеклетки на этапе имплантации.
Микоплазмоз — это инфекционное заболевание, вызванное микоплазмами, которое может затрагивать как женщин, так и мужчин. У женщин симптомы могут проявляться в виде вагинальных выделений, зуда, болезненности при мочеиспускании и дискомфорта в области таза. У мужчин заболевание часто сопровождается уретритом, болями внизу живота и проблемами с потенцией. Лечение обычно включает антибиотики, однако важно помнить, что самолечение может привести к осложнениям. Профилактика заключается в соблюдении правил личной гигиены, использовании барьерных методов контрацепции и регулярных медицинских осмотрах. Осведомленность о симптомах и своевременное обращение к врачу помогут избежать серьезных последствий.
Лечение микоплазмоза
Основная задача проводимой консервативной терапии заключается в уничтожении патогенных микроорганизмов.
С этой целью у мужчин и женщин проводится комплексное лечение микоплазмоза, которое включает в себя следующие основные звенья:
- 1) Антибиотики, которые проявляют активность в отношении данных микроорганизмов. Раньше такими являлись препараты из группы тетрациклинов. Но в настоящее время в связи с устойчивостью некоторых штаммов этих микроорганизмов к данной группе используется клиндамицин. Случаев устойчивости к нему не было выявлено. Применение Азитромицина также оправдано. К тому же этот препарат хорошо проникает внутрь лейкоцитов и сохраняется там в течение 2-3 суток, поэтому достаточно однократного приема.
- 2) Введение иммуноглобулинов пациентам, у которых ослаблен иммунитет, так как самостоятельно они не в состоянии справиться с данным воспалительным процессом.
- 3) Применение нестероидных противовоспалительных препаратов позволяет предупредить патологические изменения в органах и системах, которые развиваются на фоне воспалительной реакции, так как при урогенитальном микоплазмозе из защитной она становится повреждающей.

Осложнения микоплазмоза
Микоплазмоз и уреаплазмоз могут вызывать ряд серьезных осложнений:
- бесплодие
- внематочная беременность
- импотенция у мужчин и различные формы эректильной дисфункции
- выкидыши на ранних стадиях беременности
- преждевременные роды
- ранний разрыв плодного пузыря
- распространение воспалительного процесса на другие органы
- спаечная болезнь и другие патологические состояния.
Профилактика микоплазмоза
Профилактика урогенитального микоплазмоза является надежным способом предупредить осложнения этого патологического процесса. Она включает в себя следующие мероприятия:
- исключение случайных половых контактов
- при случайных половых связях рекомендуется использовать презерватив, который защищает от этих инфекций
- использование индивидуальных предметов личной гигиены
- регулярное посещение гинеколога для женщин и уролога для мужчин
- прохождение инфектологического обследования раз в год, если человек находится в группе риска.
В заключение необходимо отметить, что микоплазменная инфекция, поражающая половые и мочевые органы, способна приводить к развитию серьезных осложнений, а отсутствие своевременного лечения этому способствует.
В патологический процесс может вовлекаться любой орган, однако длительное время клинические проявления отсутствуют. Лечение основано на приеме антибиотиков, к которым чувствительны данные микроорганизмы, а также на проведении противовоспалительной терапии.
Но все же большое значение отводится профилактическим мероприятиям, которые позволяют предупредить заражение микоплазмами и уреаплазмами.
Диагностика микоплазмоза
Диагностика микоплазмоза представляет собой важный этап в выявлении и лечении данного заболевания, так как микоплазмы могут вызывать разнообразные клинические проявления и осложнения. Для точного определения наличия инфекции необходимо учитывать как клинические симптомы, так и результаты лабораторных исследований.
Первоначально, при подозрении на микоплазмоз, врач проводит тщательный сбор анамнеза, включая информацию о половой жизни, наличии симптомов и предшествующих заболеваниях. Важно отметить, что микоплазмоз может протекать бессимптомно, что затрудняет его раннюю диагностику.
Наиболее распространенными методами диагностики микоплазмоза являются:
- ПЦР (полимеразная цепная реакция) — это высокочувствительный и специфичный метод, позволяющий выявить ДНК микоплазм в образцах биологического материала, таких как мазки из уретры, влагалища или шейки матки. ПЦР-тесты могут обнаруживать различные виды микоплазм, включая Mycoplasma hominis и Ureaplasma urealyticum.
- Культуральный метод — включает посев образцов на специальные питательные среды для роста микоплазм. Этот метод требует больше времени, но позволяет определить чувствительность микроорганизмов к антибиотикам.
- Серологические исследования — направлены на выявление антител к микоплазмам в крови пациента. Однако этот метод менее информативен, так как наличие антител может свидетельствовать о перенесенной инфекции, а не о текущем заболевании.
После получения результатов анализов врач может установить диагноз и назначить соответствующее лечение. Важно помнить, что диагностика микоплазмоза должна проводиться в комплексе с другими инфекциями, передающимися половым путем, так как часто наблюдается их сопутствующее течение.
Кроме того, для более точной диагностики может потребоваться консультация смежных специалистов, таких как дерматовенеролог или гинеколог, особенно если у пациента имеются сопутствующие заболевания или осложнения.
Таким образом, своевременная и правильная диагностика микоплазмоза является ключевым фактором для успешного лечения и предотвращения возможных осложнений, что подчеркивает важность регулярных медицинских осмотров и тестирования на инфекции, передающиеся половым путем.
Вопрос-ответ
Какие симптомы микоплазмоза могут проявляться у мужчин?
У мужчин микоплазмоз может проявляться такими симптомами, как жжение или дискомфорт при мочеиспускании, выделения из уретры, а также боли в области половых органов. В некоторых случаях заболевание может протекать бессимптомно, что делает его диагностику сложной.
Как проводится лечение микоплазмоза?
Лечение микоплазмоза обычно включает назначение антибиотиков, таких как тетрациклины или макролиды. Важно пройти полный курс лечения, даже если симптомы исчезли, чтобы предотвратить рецидив. Также рекомендуется обследование и лечение половых партнеров для предотвращения повторного заражения.
Какие меры профилактики помогут избежать микоплазмоза?
Для профилактики микоплазмоза рекомендуется соблюдать правила личной гигиены, использовать барьерные методы контрацепции, такие как презервативы, и избегать случайных половых связей. Регулярные медицинские осмотры и тестирование на инфекции также помогут в раннем выявлении и лечении заболевания.
Советы
СОВЕТ №1
Регулярно проходите медицинские обследования. Микоплазмоз может протекать бессимптомно, поэтому важно регулярно проверяться у врача, особенно если вы находитесь в группе риска или имеете незащищенные половые контакты.
СОВЕТ №2
Обратите внимание на симптомы. Если вы заметили необычные выделения, зуд или дискомфорт в области половых органов, не откладывайте визит к врачу. Раннее выявление инфекции поможет избежать осложнений.
СОВЕТ №3
Соблюдайте правила личной гигиены. Используйте индивидуальные средства гигиены и избегайте случайных половых связей. Это поможет снизить риск заражения микоплазмозом и другими инфекциями.
СОВЕТ №4
Следуйте рекомендациям врача по лечению. Если вам поставили диагноз микоплазмоз, строго придерживайтесь назначенного курса лечения и не прерывайте его, даже если симптомы исчезли. Это поможет предотвратить рецидивы и развитие осложнений.